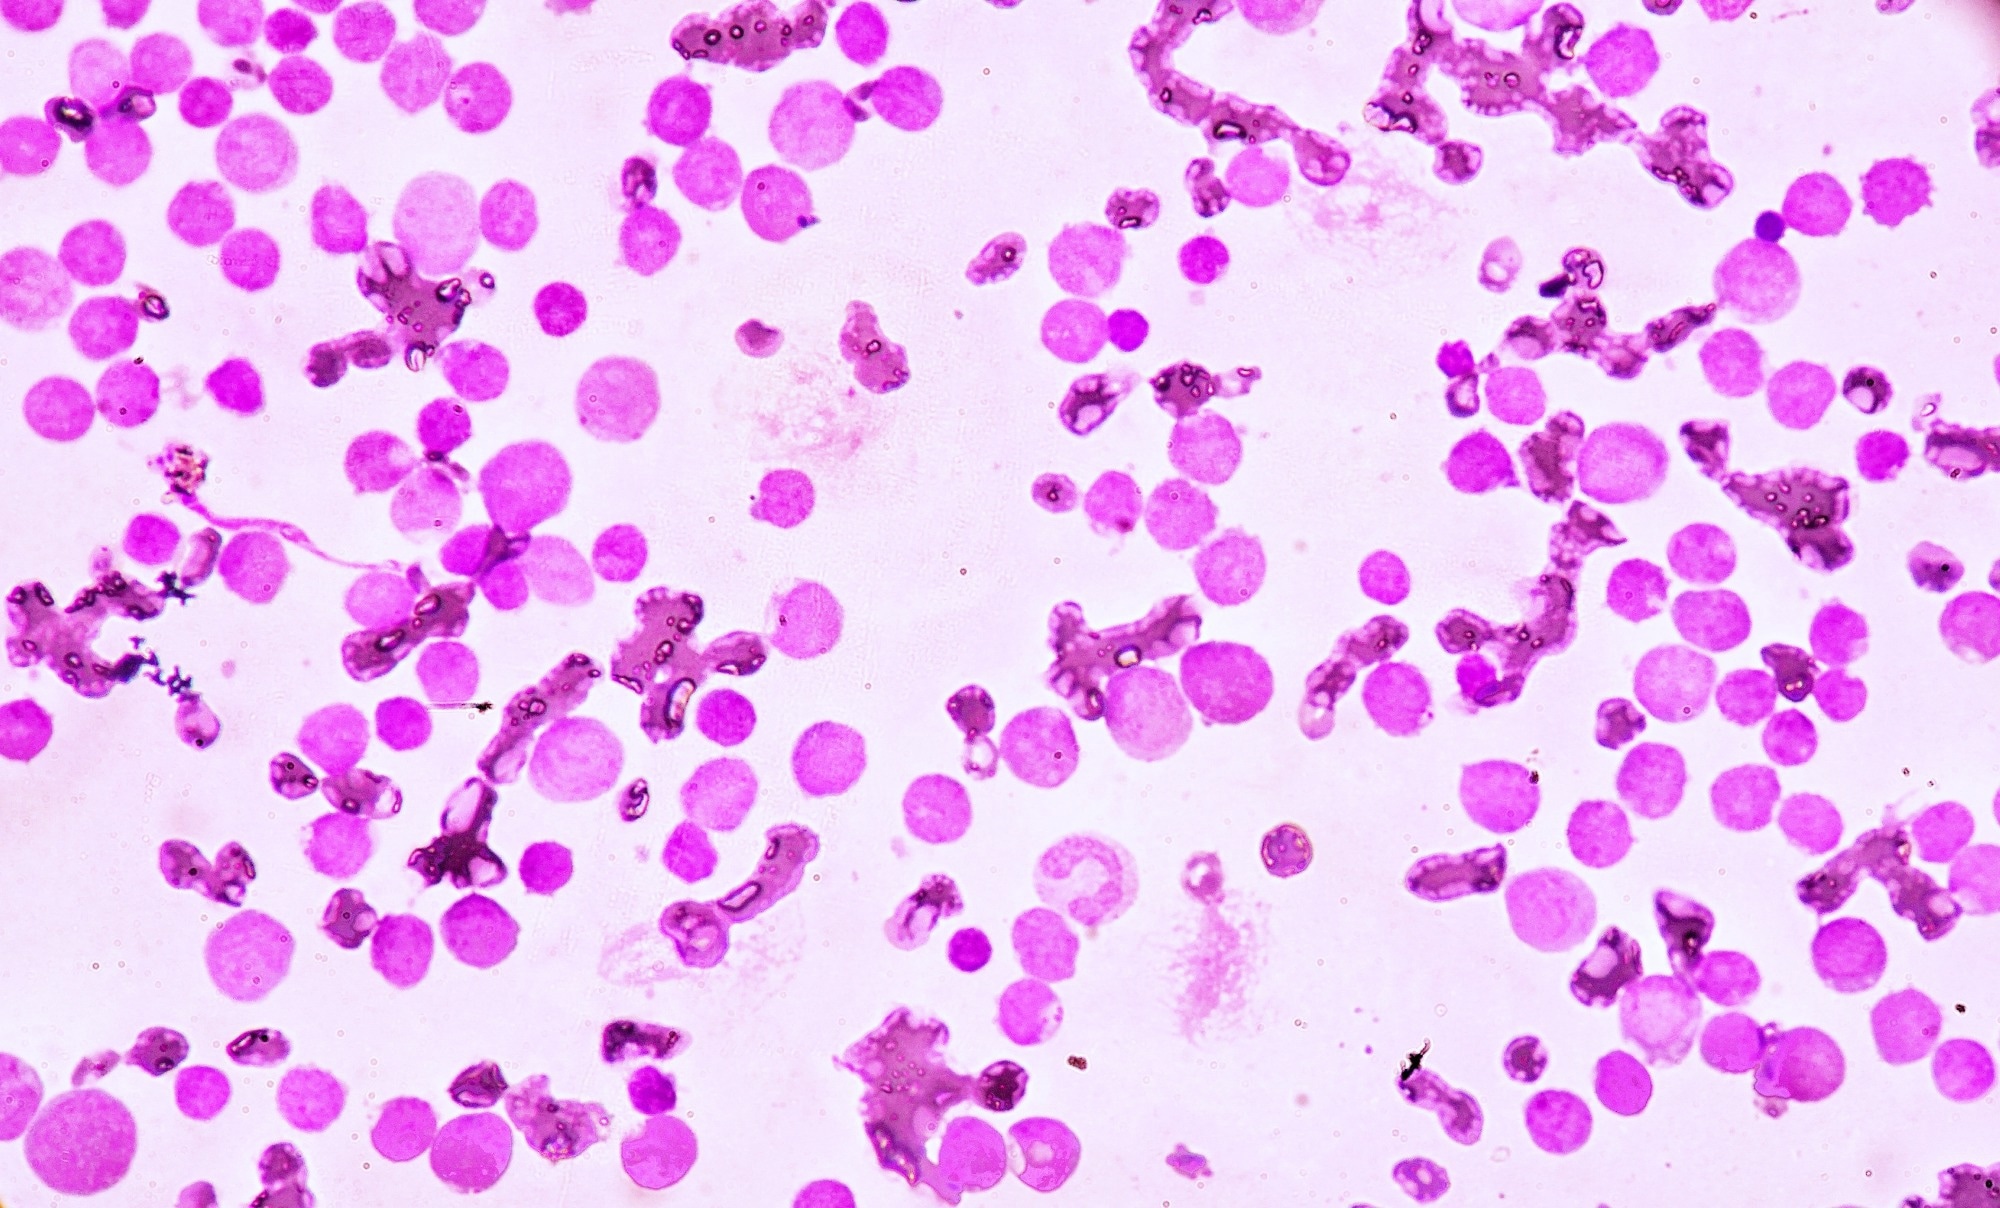
Image Credit: Medtech THAI STUDIO LAB 249/Shutterstock

Introduction
APL identification
APL morphology
Management of APL
Newly diagnosed APL
References
Further reading
Acute promyelocytic leukemia (APL) is a subtype of acute myeloid leukemia (AML) and is characterized by a unique molecular abnormality. This type of leukemia has a high mortality rate and is associated with early hemorrhagic death.
APL is relatively rare in adults; only 10-15% of adults diagnosed with AML in the United States have APL. It is more prevalent among children with AML. It is mostly associated with a high white blood cell (WBC) count of >10,000/μL as well as a higher number of toxicities related to all-trans retinoic acid (ATRA), such as pseudotumor cerebri.
 Image Credit: Nemes Laszlo/Shutterstock
Image Credit: Nemes Laszlo/Shutterstock
APL identification
APL is identified by the reciprocal translocation of chromosomes 15 and 17. The chromosome translocation causes a fusion transcript to join the promyelocyte (PML) and retinoic acid receptor-α (RAR-α) genes. Leukemic PMLs can undergo differentiation on exposure to retinoic acid, while upon exposure to arsenic trioxide, they undergo differentiation and apoptosis.
According to current recommendations, it is considered a medical emergency once APL is suspected based on blood smear morphology and/or clinical presentation. Along with other supportive measures such as platelet and cryoprecipitate administration, ATRA is administered immediately while awaiting genetic diagnosis.
Acute promyelocytic leukemia (APL) Symptoms and Diagnosis
APL morphology
In APL patients, peripheral blood smear usually shows reduced WBCs or leukopenia with circulating PMLs. These cells have plenty of irregular primary azurophilic granules.
Leukemic PMLs having multiple Auer rods are found only in the case of APL. The nuclear contour has two lobes, though it is not clearly seen due to the presence of granules. The presence of many primary azurophilic granules may not confirm APL diagnosis because leukemic cells from patients with other AML subtypes may also have such granules.
Hematologists need to thoroughly understand these fine morphologic details unique to APL as it requires prompt treatment once suspected.

 Related: The Importance of Spotting Leukemia
Related: The Importance of Spotting Leukemia
Management of APL
APL is treatable with the help of therapy targeted at the specific molecular abnormality. It is one of the very few malignant hematologic diseases that can be recognized by viewing the peripheral blood smear using a microscope.
Once APL diagnosis is suspected, ATRA is started without waiting for confirmation of diagnosis by cytogenetic or molecular studies. Initially, a standard ATRA dose of 45 mg/m2 daily in several small doses is given. This helps control coagulopathy.
In low-risk patients (i.e., WBCs <10,000/μL), ATRA therapy is continued for a few days before chemotherapy. In the case of patients at high risk (i.e., WBCs ≥10,000/μL), ATRA is combined with chemotherapy even before confirmation of APL diagnosis. In all cases of AML, regardless of subtype, anthracycline is administered while awaiting genetic confirmation.
Early administration of ATRA combined with blood product support has reduced mortality rates. The standard treatment currently used calls for anthracycline chemotherapy combined with ATRA during induction and maintenance ATRA plus low-dose chemotherapy thereafter.
Image Credit: Medtech THAI STUDIO LAB 249/Shutterstock
Image Credit: Medtech THAI STUDIO LAB 249/Shutterstock
Newly diagnosed APL
A more effective approach in patients newly diagnosed with APL is to combine ATRA treatment with arsenic trioxide. Chemotherapy can be continued minimally to keep leukocytosis under control. This new approach may replace traditional methods in the future.
Anyone newly diagnosed with AML should be considered a potential APL candidate, keeping in mind that APL differs from other subtypes, and demands urgent and aggressive medical intervention.
References
Further Reading
Last Updated: Oct 28, 2022